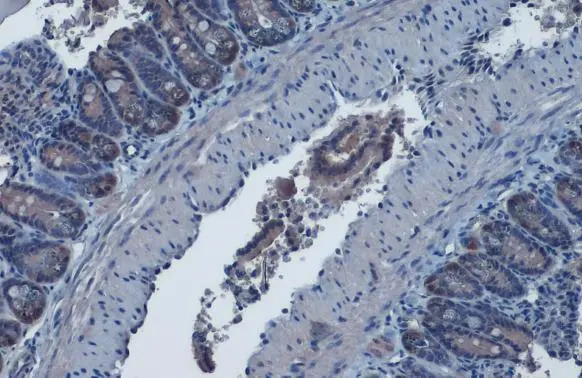
IDH1 antibody detects IDH1 protein at cytoplasm by immunohistochemical analysis. Sample: Paraffin-embedded mouse intestine. IDH1 stained by IDH1 antibody (GTX105179) diluted at 1:1000. Antigen Retrieval: Citrate buffer, pH 6.0, 15 min

PD-1 receptor-induced CD4 T cell activation and proliferation by PD-1 (mouse), mAb (blocking) (1H10) (AG-20B-0075).Method: Magnetic bead affinity purified CD4+ T cells from C57BL/6 mice are stimulated in vitro with PD-1 (mouse), mAb (b
anti-Isocitrate Dehydrogenase 1 [IDH1] (R132H Mutant) (human), mAb (AG-IHC132)
AG-20B-6024
ApplicationsELISA, ImmunoHistoChemistry
Product group Antibodies
ReactivityHuman
TargetIDH1
Overview
- SupplierAdipoGen Life Sciences
- Product Nameanti-Isocitrate Dehydrogenase 1 [IDH1] (R132H Mutant) (human), mAb (AG-IHC132)
- Delivery Days Customer10
- ApplicationsELISA, ImmunoHistoChemistry
- CertificationResearch Use Only
- ClonalityMonoclonal
- Clone IDAG-IHC132
- Gene ID3417
- Target nameIDH1
- Target descriptionisocitrate dehydrogenase (NADP(+)) 1
- Target synonymsHEL-216, HEL-S-26, IDCD, IDH, IDP, IDPC, PICD, isocitrate dehydrogenase [NADP] cytoplasmic, NADP(+)-specific ICDH, NADP-dependent isocitrate dehydrogenase, cytosolic, NADP-dependent isocitrate dehydrogenase, peroxisomal, epididymis luminal protein 216, epididymis secretory protein Li 26, epididymis secretory sperm binding protein, isocitrate dehydrogenase (NADP(+)) 1, cytosolic, isocitrate dehydrogenase 1 (NADP+), soluble, oxalosuccinate decarboxylase
- HostMouse
- IsotypeIgG1
- Protein IDO75874
- Protein NameIsocitrate dehydrogenase [NADP] cytoplasmic
- Scientific DescriptionIsocitrate Dehydrogenase 1 (IDH1) is a soluble, cytosolic enzyme involved in the TCA metabolic cycle. The most notable mutation in this enzyme, R132H, is clinically indicated in the majority of astrocytomas and oligodendroglial tumors, with the mutation being associated with more favourable prognosis and increased survival in those patients. IDH1 R132H is also useful in the differential diagnosis between anaplastic glioma and glioblastoma. This antibody is intended to qualitatively identify by light microscopy the presence of associated antigens in sections of formalin-fixed, paraffin-embedded tissue sections using IHC test methods. It has been optimized and validated using the BOND-MAX fully automated IHC&ISH stainer (see Protocol). - Monoclonal Antibody. Recognizes human IDH1 mutated at R132H. Applications: ELISA, IHC. Isotype: Mouse IgG1. Clone: AG-IHC132. Liquid. In Tris Buffer, pH 7.4, containing 1% BSA and <0.1% sodium azide. Isocitrate Dehydrogenase 1 (IDH1) is a soluble, cytosolic enzyme involved in the TCA metabolic cycle. The most notable mutation in this enzyme, R132H, is clinically indicated in the majority of astrocytomas and oligodendroglial tumors, with the mutation being associated with more favourable prognosis and increased survival in those patients. IDH1 R132H is also useful in the differential diagnosis between anaplastic glioma and glioblastoma. This antibody is intended to qualitatively identify by light microscopy the presence of associated antigens in sections of formalin-fixed, paraffin-embedded tissue sections using IHC test methods. It has been optimized and validated using the BOND-MAX fully automated IHC&ISH stainer (see Protocol).
- ReactivityHuman
- Storage Instruction2°C to 8°C
- UNSPSC41116161